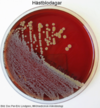

Specifika bakterier Flashcards
(89 cards)
Vilken typ av bakterie är Staphylococcus auerus?
- G+, fakultativt anaerob, kock
Hur kan vi genom tester ta reda på att det är Staphylococcus aureus?
Vad är också viktigt att göra?
Blodagarplatta (aerob), gramfärgning (G+), positiv för koagulastestning och DNas
Viktigt med resistenstypning då 5 % av aureus är MRSA

Vilken antibiotika används på Staphylococcus aureus?
-
Penicillin (hämmar alltså växande bakterieceller),
- Kan dock producera, penicillinas, som gör att man måste behandla med s.k. penicillinasstabilt penicillin t ex flukloxacillin
- Finns också meticillinresistenta Staphylococcus aureus (MRSA) – 5 %
Hur kan vi skilja på Staphylococcus aureus och epidermis?
- Aureus gulvit och epidermis gråvit på blodagarplattan
- Epidermis - negativ koagulas och inga toxiner
På vilket sätt delar man ibland upp staphylococcus?
- Koagulaspositiva och – negativa arter
Vilken är mekanismen där staphylococcus aureus kan ge främmande kroppsinfektioner?
- Främmande kroppsinfektioner (centrala infarter, proteser etc) kan bilda biofilmer, protein PIA (polysacharid intracellular adherens) viktigt (denna kan stängas av vid behov), viktigt för att bakterierna ska kunna binda till varandra och underlaget
- Staphylococcus epidermis också bra på att bilda biofilm
- Sjukhussjuka, blodförgiftning (sepsis)
- Urinvägsinfektion (adhesiner, binder hårt till urinvägsepitelet och kan därför motstå flödet)
- Hud- och sårinfektioner
- Furunkler och finnar (furunkel-karbunkel-abcess)
- Hjärtklaffsinflammation (endokardit)
- Lunginflammation (pneumoni)
- Benröta och främmandekroppsinfektioner
Vilken bakterie?
Staphylococcus aureus
Hur verkar protein A hos staphylococcus aureus?
- Förhindrar opsonisering genom att bakbinda FC-delen vilket gör att neutrofilen inte kan fagocytera (hittar inte)
- Antikomplementär
Vad visar bilden?

Streptococcus pneumoniae (diplokocker)
Vilka av Staphylococcus aureus virulensegenskaper hör till association och vilken ytterligare egenskap kan detta ha?
- Kapsel/slem (glykokalyx) (adhesion, antifagocytär)
Vilka av Staphylococcus aureus virulensegenskaper hör till makromolekylbindande cellväggsassocierade proteiner (adhesiner) och vilken funktion fyller dessa?
- Protein A (förhindrar opsonisering genom att bakbinda FC-delen vilket gör att neutrofilen inte kan fagocytera (hittar inte), antikomplementär
- Extracellulär matrix (ECM) bindande proteiner
-
Fibronektinbindande protein, Fibrinogenbindande protein, Vitronektinbindande protein, Kollagenbindande protein, Lamininbindande protein
- Ovan proteiner finns i fibrillär form i vävnad och löslig form i plasma. Detta gör att bakterien kan undvika immunförsvaret men också binda till ytor (adhesin) – multifunktionellt, också sätt att börja invadera bindväv
- Eftersom det är stora proteiner så uttrycker aureus 1-2 stycken
-
Fibronektinbindande protein, Fibrinogenbindande protein, Vitronektinbindande protein, Kollagenbindande protein, Lamininbindande protein
Vilka av Staphylococcus aureus virulensegenskaper hör till enzymer?
- Koagulas (inducerar fibrin clots)
- Katalas (omvandlar H2O2 i neutrofilernas fagolysosomer)
- DNas
- Hyaluronidas (hydroliserar hyaluronsyra i intrercellulär matrix)
- Lipaser (hydroliserar hudlipaser vilket underlättar invasion)
- Fibrinolysin (löser upp fibrin clots)
- Nukleaser (bryter ner neutrophil extracellular traps (NETs))
Vilka av Staphylococcus aureus virulensegenskaper hör till toxiner?
- A,B,G,D cytotoxiner (porformerare, “detergentlika” toxiska för många typer av celler
- Exfoliativa toxiner (ETA/ETB, serinproteaser som bryter upp intercellulär adhesion i stratum granulosum, möjligen superantigen, ger kliniskt staphylococcal scaled skin syndrome
- Enterotoxiner (familj med 9 värmestabila, smaklösa proteiner som ger matförgiftning, är superantigener), mängden viktigt
- Toxic shock syndrome toxin (TSST-1) superantigen
- Panton-Valentine leukocidin toxin (PVL) (porfomerare, toxiskt för PMN/MQ, kliniskt ses nekrotiserande hudlesioner och allvarliga pneumonier
Vad är Escherichia coli för typ av bakterie?
G-, fakultativt anaerob stav
Vad är Escherichia coli nödvändig för?
Normal matsmältning (normalflora)
Vid vilken typ av infektion är Escherichia coli vanligast?
Urinvägsinfektion
-
Enteropatogener
- EPEC (enteropatogener)
- ETEC (enterotoxiner – turistdiarré)
- EIEC (enteroinvasive – blodiga diarréer)
- EAEC (enteroaggregative)
- DEAC (diffusely adherent)
- Uropatogener – UPEC
- Meningit/sepsis – MNEC
Vilken patogen är dock viktigast att kunna och vilka exotoxiner har denna?
Vad är viktigt gällande smittspridning angående denna?
-
EHEC (enterohemorrhagic EC)
- Exotoxiner: LT och ST hos EHEC (shigella-liknande exotoxin hos EHEC
- Ehec är en sjukdomsframkallande variant av den vanliga tarmbakterien Escherichia coli. Ehec kan orsaka blodiga diarréer och ger i vissa fall allvarliga komplikationer som kan skada andra organ, främst njurarna. Ehec drabbar oftast små barn och äldre.
- Tål syra miljöer och kan därför passera magsäcken även om intaget är lågt
- Faller under smittskyddslagen
Vilka viktiga virulensfaktorer har E.coli gällande association?
Kapsel/slem
Vilka viktiga virulensfaktorer har E. coli gällande adhesionsfaktorer?
-
P-fimbrier (pyelonefritassocierade pili)
- Binder till gal-gal-innehållande glykolipid hos epitelceller i urinväg och blåsa
- Viktigt hos bakterier som orsakar pyelonefrit (90 % av stammarna, men endast 20 % av cystitorsakande stammar)
-
Typ-1-fimbrier
- Vanligare hos cystit
- Binder till mannosinnehållande komponenter (uroplakin) på värdcellen (epitel)
- Förmedlar invasion bakterien
- Binder även sIgA (viktigt för att kunna komma åt urinvägsepitelet), Tamm-Horsfall protein (uromodulin; värdförsvarsprotein), slemhinna och granulocyter
Vilka viktiga virulensfaktorer har E. coli utöver association,adhesionsfaktorer, LPS, kapsel och flageller?
- Hemolysin – membranförstörande exotoxiner (erytrocyter), även adhesion
- Sideroforer
-
Typ-III sekretion
- Proteinkomplex i cellväggen hos vissa G-, bakterien kan injicera proteiner in i en eukaryot cell
Vilka viktiga virulensfaktorer har E. coli gällande LPS?
-
LPS (lipid-A framför allt) är starkt inflammationsinducerande (hos de flesta G-)
- binds till CD14 och TLR-4 som aktiverar transkriptionsfaktorn NF-kappa-B vilket ger cytokinerna TNF-alfa, IL-1-beta och IL-6. Detta leder till ett inflammationssvar både i urinvägarna (pyuri) och ofta generellt (feber och CRP-stegring)
- Även komplementaktiverande
- Kan också leda till trombocytepeni och cirkulationstörnning
- O-antigen som motverkar fagocytos (eftersom den är variabel) och stimulerar till inflammation (antikroppar),
Vilka viktiga virulensfaktorer har E. coli gällande kapsel och rörlighet?
- Polysackaridkapsel (K-antigen) som motverkar fagocytos
- H-antigen (flageller)
Vilka fem bakterier hör till “the five killers”?

Vad är Streptococcus pyogenes (grupp A streptokocker) för typ av bakterie?
-
G+ kocker, fackultativt anaerob
- Kan leva intracellulärt
- Lite mer känsliga än Staphylococcus













